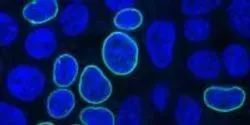

Content by Johns Hopkins Medicine
Filter by
AllArticlesAudioEbooksEventsInfographicsNewsProductsSurveysDocumentsVideosVirtual EventsWebinars
The scientists say the method, which they based on tests with mouse embryos and thousands of human cells, could improve consistency and efficiency of genome editing
| 4 min read
























